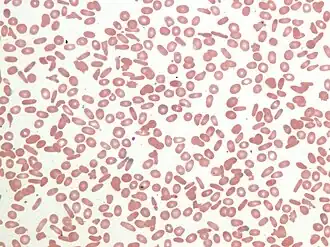

Anemia hemolítica
| Anemia hemolítica | |
|---|---|
| |
| Sangue periférica com hemácias elípticas características da eliptocitose hereditária. | |
| Especialidade | hematologia |
| Classificação e recursos externos | |
| CID-11 | 3A4Z |
| CID-10 | D55-D59 |
| CID-9 | 282, 283, 773 |
| OMIM | 266120, 612631 |
| DiseasesDB | 5534 |
| MedlinePlus | 000571 |
| eMedicine | med/979 |
| MeSH | D000743 |
Anemia hemolítica (do grego antigo haemo sangue, lysis ruptura) é uma anemia devido à ruptura das hemácias (hemólise) antes da sua vida normal de 120 dias. Essa ruptura anormal de hemácias pode ocorrer nos vasos sanguíneos (hemólise intravascular) ou em outro lugar do corpo (extravascular). Ela possui diversas causas, podendo ser inofensiva ou até mesmo ameaçar a vida. A classificação geral da anemia hemolítica é a de sua origem se é adquirida ou idiopática. O tratamento depende da causa e natureza da quebras das hemácias.
Causas
A Anemia hemolítica pode ser congênita ou adquirida.
- Congênita[1]
- Defeitos da membrana dos glóbulos vermelhos: esferocitose hereditária e esferocitose hereditária.
- Defeitos na produção de hemoglobina: talassemias, anemia falciforme e anemia diseritropoiética congênita (essa última registrou o primeiro paciente curado recentemente).[2]
- Metabolismo defeituoso dos glóbulos vermelhos: deficiência de glucose-6-fosfato desidrogenase e na deficiência de piruvato quinase.
- Adquirida[1]
- Autoanticorpos: anemia hemolítica autoimune, doença hemolítica do recém-nascido, pós-micoplasmose ou pós-mononucleose
- Hemoglobinúria paroxística noturna: um raro tipo de anemia hemolítica intravascular induzida pelo sistema complemento.
- Reação transfusional: ao receber sangue incompatível;
- Infecção: Malária, Escherichia coli enterotóxico, Streptococcus hemolíticos
- Linfomas e Leucemia linfoide crônica
- Prótese de válvula cardíaca: anemia hemolítica leve em 70% e severa em 3%.[3]
- Efeito colateral de medicamentos: como acetaminofen, penicilinas, clorpromazina, ibuprofeno, interferon alfa, procainamida, quinina ou rifampicina.
- Intoxicação por chumbo (Saturnismo).
Sinais e sintomas
Pacientes com anemia hemolítica leve recente ou moderada de longa duração podem ser assintomáticos. Os sintomas de anemia moderada são [4]:
- Fraqueza e cansaço;
- Palidez ou pele amarelada;
- Falta de apetite;
- Tontura e sonolência;
- Taquicardia com hipotensão;
- Respiração acelerada, falta de ar.
Pedras vesiculares de bilirrubina podem se formar em anemias severas. Esplenomegalia (aumento do baço) pode estar presente nas leucemias, linfomas e na esferocitose hereditária. Hemólise intravascular pode causar escurecimento da urina.
Diagnóstico
Quando a clínica gera suspeita de anemia sem causa hemorrágica o primeiro a fazer é analisar uma gota de sangue periférico ao microscópio (esfregaço de sangue). Dentre testes de laboratórios que podem ajudar a identificar o tipo de anemia hemolítica estão:
- Contagem de reticulócitos absolutos
- Teste de Coombs, direto e indireto
- Teste de Donath-Landsteiner
- Aglutininas frias
- Hemoglobina livre no soro ou na urina
- Hemossiderina na urina
- Contagem de plaquetas
- Eletroforese de proteínas séricas
- Piruvato quinase
- Níveis séricos de haptoglobina
- Lactato desidrogenase sérica (LDH)
Tratamento
O tratamento sintomático pode ser dado por transfusão de sangue, se houver anemia marcada. Um teste de Coombs positivo (indica autoimunidade) é uma contra-indicação relativa para transfundir o paciente. Na anemia hemolítica fria, existe vantagem na transfusão de sangue aquecido. Em casos de anemia hemolítica autoimune, a terapia com esteroides ou imunoglobulinas IV pode ser necessária. [5]
Remover parte do baço pode ser necessário quando ele for responsável pela destruição massiva de hemácias, como na esferocitose hereditária.[6]
Em anemias de rápida evolução se administra eritropoietina com suplemento oral de ácido fólico, vitamina B12 e ferro para suprir os nutrientes que estão sendo perdidos.
Referências
- ↑ a b Dr Hayley Willacy, Dr Laurence Knott e Dr Hannah Gronowhttp. Haemolytic Anaemia. patient.info/doctor/haemolytic-anaemia
- ↑ «Primeiro Paciente Curado De Anemia Diseritropoiética Congênita». Bone Marrow Transplantation. 21 de março de 2017. Consultado em 21 de março de 2017
- ↑ Wise, Donald Lee (2000). "Biomaterials Engineering and Devices: Orthopedic, dental, and bone graft applications". ISBN 978-0-89603-859-2.
- ↑ http://www.healthline.com/health/hemolytic-anemia
- ↑ Medline plus. Hemolytic anemia treatment. https://medlineplus.gov/ency/article/000571.htm
- ↑ http://www.medicalassistantonlineprograms.org/hemolytic-anemias/